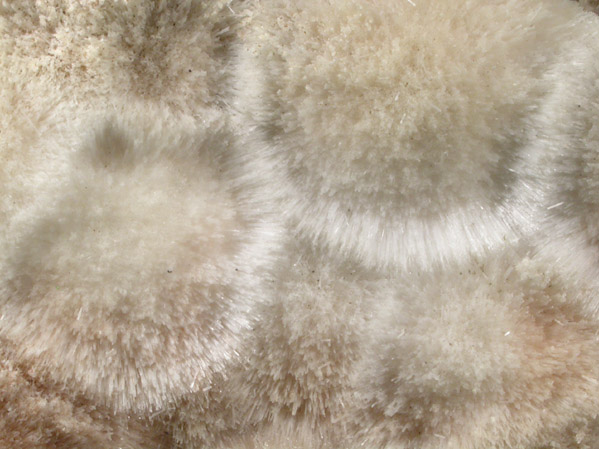

| AllMinerals/JohnBetts-FineMinerals > Online Mineral Museum Photographic Archive > Minerals from New Jersey > Natrolite-Mesolite |
 |
|
 |
 |
| DESCRIPTION: | No. 53461 |
| Mineral: | Natrolite-Mesolite |
| Locality: | Lower New Street Quarry, Paterson, Passaic County, New Jersey |
| Description: | Large plate of acicular white natrolite-mesolite crystals with minor matrix attached to the bottom. The specimen is labeled as natrolite, but Sinkankas and Tschernich both state that mesolite is found at the locality, and often mislabeled as natrolite. Ex. Joe Cilen (1916-1997) #1968 |
| Overall Size: | 13x10x4 cm |
| Crystals: | 10-20 mm |
| Archived: | For reference only |
© AllMinerals/JohnBetts-FineMinerals All Rights Reserved
The minerals illustrated on this site are presented for reference purposes only. The owner of this site did not collect the minerals and collectors should not assume access is permitted to the property based on inclusion in this museum. Please contact the property owner to obtain legal permission before entering private property.